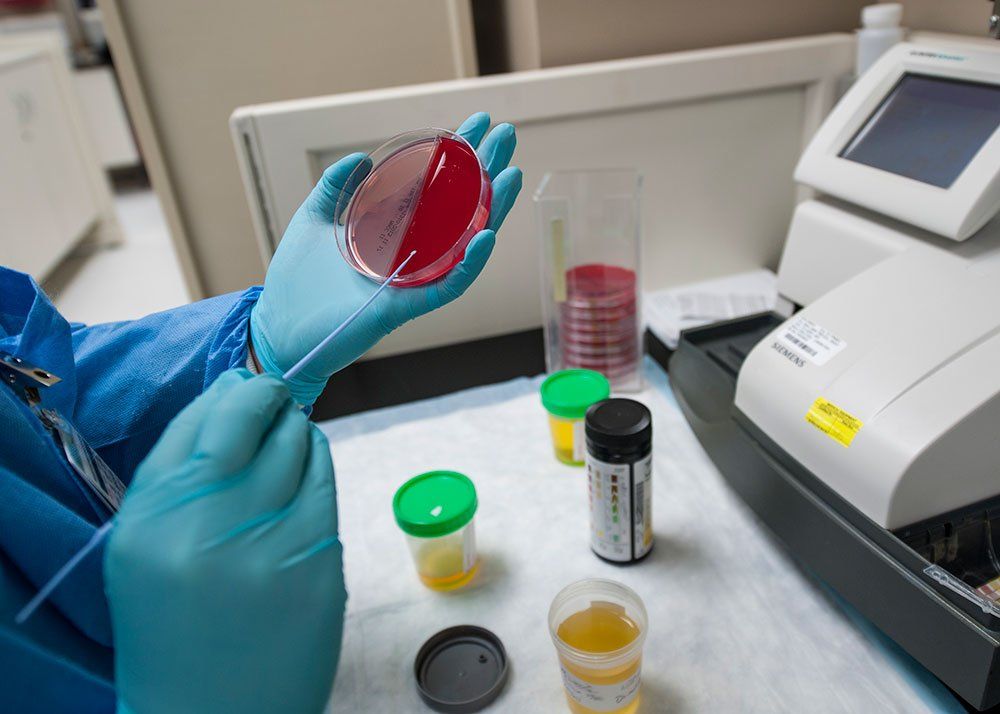

Сопли у собаки могут указывать на заболевания или аллергии, и их появление требует внимания владельца. В этой статье рассмотрим девять причин насморка у собак и эффективные методы лечения в домашних условиях. Знание этих факторов поможет своевременно распознать проблему и предпринять меры для здоровья и комфорта вашего питомца.
Признаки ринита у собак
Определить наличие этой болезни можно по следующим симптомам:
- Выделения из носа. В начале заболевания выделения прозрачные и жидкие (серозные), но по мере прогрессирования болезни они становятся более густыми. В некоторых случаях может наблюдаться гнойный экссудат, который имеет желтоватый или зеленоватый оттенок.
- Затрудненное дыхание. Слизистые оболочки носа у собаки отекают, что приводит к сопению и хрюканью. Если нос сильно забит, питомец начинает дышать ртом.
- Чихание.
- Повышенная температура, кашель и слезотечение. Эти симптомы могут возникнуть, если у вашего питомца вирусная инфекция.
- Проблемы со сном. Из-за сильной заложенности носа животное может плохо спать и громко храпеть.
- Потеря аппетита, снижение веса и апатия. Эти признаки могут указывать на хроническую форму заболевания.
Собачий насморк может быть вызван различными факторами, и эксперты выделяют девять основных причин. Среди них аллергии, инфекции верхних дыхательных путей, инородные тела, а также хронические заболевания. Важно отметить, что сопли могут быть признаком более серьезных проблем, таких как пневмония или опухоли. Лечение в домашних условиях может включать промывание носа солевыми растворами, использование увлажнителей воздуха и обеспечение комфортной температуры в помещении. Однако, если симптомы не проходят в течение нескольких дней или сопровождаются другими признаками, такими как кашель или потеря аппетита, необходимо обратиться к ветеринару для более точной диагностики и назначения адекватного лечения. Забота о здоровье питомца требует внимательности и своевременного реагирования на изменения в его состоянии.
https://youtube.com/watch?v=3AH5E2ISu6g
Причины насморка
Чтобы знать, как лечить насморк у пса, нужно выяснить, почему он появился. У этой болезни может быть много причин. Они бывают физиологическими и патологическими. Первые не требуют лечения, но подразумевают наблюдение за собакой. Вторые провоцирующие факторы должны быть как можно скорее устранены, иначе они обернутся серьезными проблемами для животного.

| Причина насморка | Симптомы | Рекомендации по лечению (домашние) |
|---|---|---|
| 1. Аллергия | Чихание, прозрачные выделения из носа, зуд, покраснение глаз, иногда кашель. | Исключить аллерген, промывание носа физраствором, антигистаминные препараты (по назначению ветеринара). |
| 2. Простуда (вирусная инфекция) | Прозрачные или беловатые выделения, чихание, кашель, вялость, снижение аппетита, повышение температуры. | Теплое питье, покой, увлажнение воздуха, промывание носа физраствором, витамины. |
| 3. Бактериальная инфекция | Желтые, зеленые, густые выделения из носа, неприятный запах, лихорадка, вялость. | Антибиотики (только по назначению ветеринара), промывание носа антисептическими растворами (например, отваром ромашки). |
| 4. Инородное тело в носу | Внезапное чихание, односторонние выделения (часто с кровью), собака трет нос лапой, беспокойство. | Немедленное обращение к ветеринару для извлечения инородного тела. |
| 5. Грибковая инфекция | Хронические выделения (часто с кровью), деформация носа, боль, потеря аппетита. | Противогрибковые препараты (только по назначению ветеринара), промывание носа. |
| 6. Стоматологические проблемы | Односторонние выделения из носа, неприятный запах изо рта, боль при жевании, отек морды. | Лечение основного заболевания зубов у ветеринара. |
| 7. Опухоли в носовой полости | Хронические, часто кровянистые выделения, затрудненное дыхание, деформация носа, потеря веса. | Диагностика и лечение у ветеринара (хирургия, химиотерапия). |
| 8. Сухой воздух | Сухие, иногда кровянистые корочки в носу, чихание. | Увлажнение воздуха в помещении, промывание носа физраствором. |
| 9. Раздражающие вещества (дым, пыль, химикаты) | Чихание, прозрачные выделения, покраснение слизистых. | Устранение источника раздражения, проветривание помещения, промывание носа физраствором. |
Интересные факты
Вот несколько интересных фактов о насморке у собак и его причинах:
-
Анатомия носа: У собак носовая полость устроена так, что она может улавливать и фильтровать запахи гораздо эффективнее, чем у человека. Это делает их более подверженными инфекциям и аллергиям, что может привести к образованию соплей. Их чувствительная слизистая оболочка может реагировать на различные раздражители, включая пыль, пыльцу и химические вещества.
-
Аллергии и сезонные изменения: Как и у людей, у собак могут развиваться аллергии на пыльцу, пыль или даже определенные продукты. В сезон цветения многие собаки страдают от насморка, что может быть связано с аллергической реакцией. Это подчеркивает важность наблюдения за состоянием питомца в разные времена года.
-
Заболевания и инфекции: Насморк у собак может быть признаком более серьезных заболеваний, таких как инфекционные болезни (например, парагрипп или инфекционный бронхит). Важно не игнорировать симптомы и при необходимости обращаться к ветеринару, так как некоторые инфекции могут требовать специфического лечения.
Эти факты подчеркивают важность внимательного отношения к здоровью собак и понимания причин, которые могут вызывать насморк.
Инородное тело в носу
Изучая новые места или предметы, ваш питомец может случайно вдохнуть мелкие детали, такие как части детской игрушки, камешки, нитки или травинки. Когда слизистая оболочка носа раздражается, у собаки увеличивается выработка секрета, который начинает выделяться из носовых проходов – это естественная реакция организма на попытку избавиться от инородного объекта. Если слизистая повреждена, в выделениях могут появиться красные прожилки – кровь. В такой ситуации собака начинает чихать, активно тереть нос лапой и трясти головой.
Вирусная инфекция
При проникновении в собачий организм вируса появляется насморк. Из ноздрей у пса постоянно вытекают прозрачные сопли, вокруг мочки образуются корочки, обильно текут слезы, он чихает и кашляет, отказывается от пищи, становится апатичным и не реагирует на внешние раздражители. Со временем у питомца повышается температура тела, он тяжело хрипит. Игнорирование симптомов вирусной инфекции может закончиться гибелью животного.
Бактериальное поражение
Бактериальные инфекции не являются самой распространенной причиной ринита у собак. Наиболее подвержены этим заболеваниям щенки, ослабленные животные и собаки с низким уровнем иммунной защиты. Инфекции, вызванные бактериями (такие как туберкулез, туляремия, бруцеллез и другие), могут проявляться следующими симптомами:
- выделения из носовых пазух и глаз, которые могут быть серозными, гнойными или гнойно-серозными;
- резкое повышение температуры;
- общая слабость;
- потеря аппетита;
- кашель;
- бледность слизистых оболочек;
- ухудшение состояния шерсти;
- кожные поражения.
Грибковая инфекция
Для инфекций, вызванных грибками, характерны мутные выделения мажущей консистенции из одной или обеих ноздрей. Подобные заболевания развиваются стремительно и трудно поддаются лечению. Не следует пытаться помочь питомцу в домашних условиях. Неумелые действия лишь усугубят состояние пса, а потерянное время может привести к его гибели. Лечение разумнее доверить ветеринару.
Аллергическая реакция
Когда животное сталкивается с аллергеном, который может быть как пищевым продуктом, так и лекарственным средством, бытовой химией, слюной паразитов, пылью или пыльцой растений, у него может возникнуть аллергическая реакция. Первые симптомы аллергии обычно включают насморк и слезотечение. Аллергический ринит может также проявляться кашлем, сильным зудом и отеками. В данном случае выделения из носа имеют серозный характер.
Раздражение слизистой оболочки (контакт с едкими химикатами, табачным дымом и т. д.)
При вдыхании собакой паров едких химических веществ, табачного дыма, парфюма хозяина она может начать кашлять и чихать. При этом у нее из носовых ходов обильно течет прозрачная жидкость. Это неопасное состояние. Оно вызвано раздражением слизистой оболочки носа. Достаточно устранить раздражающий фактор (проветрить комнату, вывести питомца из помещения), и у пса исчезнут неприятные симптомы.
Новообразования в носовых ходах
Ринит может возникнуть из-за наличия новообразований в носовой полости, таких как полипы или опухоли, как доброкачественные, так и злокачественные. Эти наросты в области носоглотки затрудняют нормальную циркуляцию воздуха, что приводит к развитию насморка. О положительном результате лечения можно говорить только при условии своевременного удаления образований. В случае запущенных злокачественных опухолей шансы на выживание для питомца значительно снижаются.
Аномальное строение носа
Аномалии строения носа, мешающие полноценному дыханию и провоцирующие ринит, делятся на врожденные и приобретенные в результате травмы или хирургического вмешательства. К подобным дефектам относят деформации носовой перегородки, челюстей и неба. Они устраняются хирургическим способом. Врожденные аномалии обычно встречаются у представителей собачьих пород с укороченным носом (бульдогов, мопсов и других брахицефалов).
Травмы и последствия операции
Травмы носа и неправильно выполненные хирургические процедуры у животных могут привести к деформации носовой перегородки, челюстей или неба. Изменения в структуре этих органов могут вызвать затруднения с дыханием, что, в свою очередь, приводит к хроническому насморку. У собаки может наблюдаться постоянное выделение серозной жидкости из носа. Деформации не всегда заметны визуально; зачастую их можно обнаружить только с помощью риноскопии. Решение этих проблем возможно исключительно через хирургическое вмешательство.
Повреждения слизистой оболочки носовой полости также могут возникать в результате травм или операций. В таких случаях у животного могут появляться выделения с соплями, содержащими кровяные примеси.
Диагностика заболевания, вызвавшего насморк
Вылечить насморк у пса без предварительного выяснения причины его появления не всегда возможно. Перед тем как направить четвероногого пациента на диагностические обследования (анализы, риноскопию, рентгеновский снимок и т. д.), ветеринар осматривает его и анализирует сведения, полученные от хозяина пса, о том, какими болезнями болел его питомец в прошлом и что предшествовало появлению у него соплей. Информация о том, какие манипуляции осуществляются в ходе диагностики болезни, размещена в таблице:
| Диагностические процедуры | Цель проведения | |
| Лабораторные | Анализ крови и мочи | Оценка состояния животного. Выявление признаков воспалительного процесса. |
| Анализ сыворотки крови | Выявление антител. | |
| Копрограмма | Выявление и определение вида паразитов. | |
| Коагулограмма | Изучение свертываемости крови перед проведением биопсии. | |
| Исследование смывов из носовой полости | Изучение микробного состава и количественного соотношения микрофлоры носоглотки. | |
| Гистологическое исследование | Выявление раковых клеток. | |
| Инструментальные | Риноскопия | Изучение строения носовой полости. Выявление аномалий, новообразований, наличия инородных тел. |
| МРТ | ||
| Рентгенография лицевого отдела черепа | ||
Большинство исследований, например биопсия, риноскопия, МРТ, проводятся под наркозом. Животное надо правильно подготовить к диагностическим процедурам.
Как помочь питомцу в домашних условиях?
После анализа результатов исследования и установления точного диагноза ветеринарный врач разрабатывает план лечения. В большинстве случаев, если не требуется хирургическое вмешательство при обнаружении опухолей или деформаций в области носоглотки, животное отправляется на лечение домой. В домашних условиях владельцы должны промывать и прогревать нос питомца, закапывать капли и давать назначенные лекарства. Кроме медикаментозной терапии, для быстрого восстановления собаке необходим специальный уход и правильное питание.
Промывание и прогревание носа
Перед тем как промыть питомцу нос, его надо почистить от корочек. Чтобы эффективно прочистить носовые ходы, надо использовать ватную палочку, смоченную теплой кипяченой водой или перекисью водорода. Затем их следует промыть. Делают это с помощью физраствора или средств для промывания носа у людей, предварительно подогретых до температуры тела животного. Промывают носовые ходы жидкостью из небольшой резиновой груши или шприца без иглы. При проведении манипуляции нужно следить за тем, чтобы раствор не попал питомцу в рот.
Для ускорения выздоровления рекомендуется делать прогревание. Обычно эту манипуляцию назначают при хроническом заболевании.
Чтобы прогреть питомцу нос, надо холщовый мешок с солью погреть на сухой сковороде, чтобы он стал теплым, после чего приложить к носовой перегородке на 5–10 минут.
Капли и другие ветпрепараты
Капли помогают устранить патологическую флору в носу и облегчают дыхание, снижая отечность. При диагностировании основного заболевания ветеринар может назначить специальные препараты для устранения его симптомов. Их следует применять строго по указаниям специалиста. В таблице приведены рекомендации по каплям для собак с насморком, а также дополнительные лекарства:
| Лечение насморка у собак | Ветеринарные препараты | |
| Основные | Капли | Максидин, Фурацилин, Анандин. Не рекомендуется использовать капли «Нафтизин», «Галазолин» и «Санорин». |
| Иммуномодуляторы | Риботан, Иммунофан, Циклоферон, Гамавит | |
| Витамины | А, Е, С | |
| Дополнительные | Антигистаминные (назначаются при наличии аллергии) | Супрастин, Лоратадин, Тавегил |
| Антибактериальные (используются, если из носа выделяется гной) | Цефтриаксон |
Уход и питание
При уходе за больным псом и его кормлении во время лечения надо:
- поместить животное в теплое помещение;
- позаботиться о влажности воздуха в комнате, в которой находится больной четвероногий друг, – ее уровень не должен быть меньше 60%;
- исключить пребывание собаки на сквозняке;
- обеспечить питомцу покой;
- сократить время прогулок;
- ввести в собачий рацион продукты, богатые витаминами А и С;
- пищу давать в теплом жидком виде – если собака питается готовым кормом, его следует предварительно размачивать в теплой воде;
- обильно поить животное – вода должна быть комнатной температуры.
Профилактика насморка у собаки
Чтобы предотвратить возникновение данной проблемы, следует придерживаться нескольких рекомендаций:
- избегайте разброса мелких деталей игрушек и других предметов по дому, которые могут оказаться в носу вашего питомца;
- после прогулок проверяйте нос собаки на наличие посторонних предметов;
- регулярно проводите профилактические ветеринарные осмотры;
- незамедлительно лечите выявленные заболевания;
- защищайте животное от переохлаждения, особенно в холодное время года, выгуливая короткошерстных собак в теплых костюмах;
-
не забывайте о регулярной дегельминтизации и вакцинации;
-
обеспечивайте питомца качественным питанием;
- если вы кормите собаку готовыми кормами, согласуйте их выбор с ветеринаром;
- при натуральном питании регулярно добавляйте витаминные комплексы;
- храните бытовую химию и медикаменты в недоступных для животных местах;
- избегайте курения и распыления туалетной воды в присутствии собаки;
- исключите контакт питомца с потенциальными аллергенами;
- ограничивайте общение собаки с бездомными животными;
- следите за тем, чтобы питомец не подбирал еду и незнакомые предметы с земли во время прогулок;
- выбирайте проверенных партнеров для вязки.

Когда обращаться к ветеринару
Когда у вашей собаки появляются сопли, важно внимательно следить за ее состоянием и определять, когда необходимо обратиться к ветеринару. Сопли могут быть признаком различных заболеваний, и в некоторых случаях игнорирование симптомов может привести к серьезным последствиям для здоровья питомца.
Первым признаком, который должен вас насторожить, является продолжительность насморка. Если сопли у собаки не проходят в течение нескольких дней, это может указывать на наличие инфекции или другого заболевания, требующего медицинского вмешательства.
Обратите внимание на цвет и консистенцию выделений. Прозрачные сопли могут быть признаком аллергии или легкой простуды, тогда как желтые или зеленые выделения могут указывать на бактериальную инфекцию. Если сопли имеют кровянистый оттенок, это также является серьезным сигналом, требующим немедленного обращения к ветеринару.
Дополнительные симптомы, такие как кашель, чихание, потеря аппетита, вялость или повышение температуры, также могут указывать на необходимость визита к специалисту. Если ваша собака проявляет признаки дискомфорта, такие как частое трение носом о поверхность или чрезмерное слюноотделение, это также может быть поводом для беспокойства.
Если у собаки наблюдаются сопли в сочетании с другими симптомами, такими как затрудненное дыхание или отек лица, это может указывать на более серьезные проблемы, такие как аллергическая реакция или инфекция дыхательных путей. В таких случаях необходимо немедленно обратиться к ветеринару.
Не забывайте, что некоторые породы собак более предрасположены к респираторным заболеваниям, и их владельцам следует быть особенно внимательными к любым изменениям в состоянии здоровья питомца. Важно помнить, что ранняя диагностика и лечение могут значительно улучшить прогноз и ускорить выздоровление вашей собаки.
Вопрос-ответ
Какие основные причины насморка у собак?
Основные причины насморка у собак могут включать аллергии, инфекции верхних дыхательных путей, инородные тела в носу, синусит, а также заболевания, такие как парагрипп или инфекционный ринит. Также насморк может быть вызван воздействием химических веществ или пыли в окружающей среде.
Как можно помочь собаке с насморком в домашних условиях?
Для облегчения состояния собаки с насморком можно использовать паровые ингаляции, обеспечивать доступ к свежему воздуху и увлажнять помещение. Также важно следить за гидратацией питомца и при необходимости давать ему теплые бульоны. Однако, если симптомы не проходят или ухудшаются, следует обратиться к ветеринару.
Когда стоит обратиться к ветеринару при насморке у собаки?
Обратиться к ветеринару следует, если насморк сопровождается другими симптомами, такими как высокая температура, сильный кашель, затрудненное дыхание, потеря аппетита или если выделения из носа имеют необычный цвет или запах. Эти симптомы могут указывать на более серьезные заболевания, требующие профессионального лечения.
Советы
СОВЕТ №1
Обратите внимание на цвет и консистенцию выделений. Прозрачные сопли могут указывать на аллергическую реакцию, тогда как зеленые или желтые выделения могут свидетельствовать о бактериальной инфекции. Это поможет вам лучше понять, когда необходимо обратиться к ветеринару.
СОВЕТ №2
Следите за общим состоянием вашей собаки. Если, помимо насморка, у питомца наблюдаются такие симптомы, как кашель, потеря аппетита или вялость, это может быть признаком более серьезной проблемы, требующей ветеринарного вмешательства.
СОВЕТ №3
Создайте комфортные условия для вашей собаки. Убедитесь, что в помещении, где она находится, нет сквозняков и холодного воздуха. Также можно использовать увлажнитель воздуха, чтобы облегчить дыхание и уменьшить раздражение слизистых оболочек.
СОВЕТ №4
Не забывайте о профилактике. Регулярные прогулки на свежем воздухе, сбалансированное питание и своевременные прививки помогут укрепить иммунитет вашей собаки и снизить риск возникновения респираторных заболеваний.